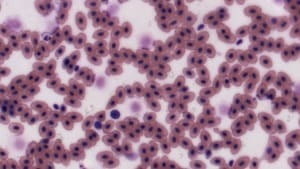
Brightness Filter — Before

Information in this article applies to:
Article ID: NFL1040 — Created: 5 May 2017 — Reviewed: 13 Dec 2020
What does the brightness filter do?
Brightness is the overall lightness or darkness of an image. The brightness filter adjusts the brightness or darkness of an image by increasing or decreasing every pixel's RGB values by the specified adjustment value.
Brightness Filter — Before

Brightness Filter — After
The brightness filter controls allow you to adjust the brightness between -50 (darkest) and +50 (brightest).
Images require proper contrast and brightness for best viewing. When brightness is too high, bright parts of the image are saturated and the detail in those areas is lost. When brightness is too low, dark parts of the image become black and detail is lost.
Note
Brightness can also be affected by the Look-Up Table Filter.